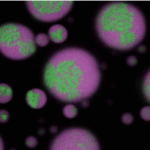

2025-07-07 カリフォルニア大学サンディエゴ校 (UCSD)
<関連情報>
- https://today.ucsd.edu/story/voracious-honey-bees-threaten-the-food-supply-of-native-pollinators
- https://resjournals.onlinelibrary.wiley.com/doi/10.1111/icad.12858
外来種の野生ミツバチによる花粉搾取: 種間競争の潜在的影響 Pollen exploitation by non-native, feral honey bees: Potential consequences for interspecific competition
Dillon J. Travis, Joshua R. Kohn, David A. Holway, Keng-Lou James Hung
Insect Conservation and Diversity Published: 07 July 2025
DOI:https://doi.org/10.1111/icad.12858

Abstract
- The globally distributed western honey bee (Apis mellifera) can reach high local abundances in both its native and introduced ranges. For instance, previous studies documented that honey bees outnumber the sum of all other floral visitors to native vegetation in Southern California.
- To quantify potential resource competition exerted by honey bees, we used plant-pollinator network data to estimate the abundance and biomass of honey bees and native bees, and pollen removal experiments to estimate the amount of pollen removed by honey bees.
- Honey bee biomass constituted 98% of total bee biomass across our study sites. Just two visits by honey bees resulted in the removal of more than 60% of available pollen produced by three common native plants (Salvia mellifera, S. apiana and Phacelia distans), and 80% of pollen was removed by the end of one day for each of the three species.
- Based on documented relationships between pollen provision mass and bee body mass, we estimated that pollen removed by honey bees from these three plant species could produce many dozens to thousands of native bees of average size per hectare per day.
- Our findings illustrate the potential for strong exploitative competition between honey bees and native bees, and underscore that resource consumption by honey bees should receive greater attention as a potential factor contributing to pollinator declines.